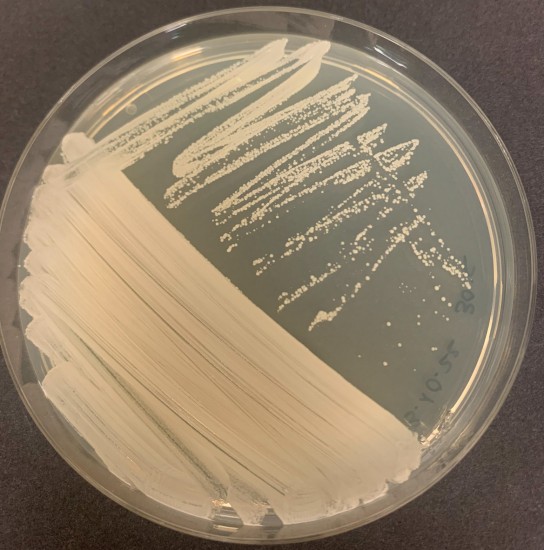

| Name |
Nesterenkonia halobia (Onishi and Kamekura 1972) Stackebrandt et al. 1995 |
|
| Strain designation | DSM 20541 |
|
| Other collections | ATCC 21727; CCM 2591; H. Onishi 28-3; NCIMB 2204 |
|
| Access in situ (sampling data) | Source: Unrefined solar salt Country of access: Unknown Date of access: Before 18-10-1971 |
|
| History | CECT, 1992 < J.L. Fernández Puentes, Pharmamar SA, Spain < DSMZ < CCM < H. Onishi, Japan |
|
| Growth conditions | Culture media: 3 Nutritional requirements: Add 6% (w/v) NaCl to medium M.3 Growth temperature (in °C): 30 Incubation time: 72h Atmospheric needs: aerobic Cultivation conditions for CECT strains |
|
| Restrictions | Risk group: 1 CECT MTA |
|
| Cell wall constituents | Murein: A3alpha L-Lys-Gly-L-Ala2 |
|
| Genetic data | G+C mol%: 71.5% 16S rRNA sequence: X80747 |
|
| Patents | US patent 3767530, production of halophilic alpha-amylase |
|
| Delivery | | Freeze-dried culture | | Acticult® 3R | | Active culture rate A | | Genomic DNA |
Tarifas de presentaciones |
|
Temperature: 30.0°C CECT Culture medium 3: Corynebacterium BROTH/AGAR (4d) Remarks: M.3 + 6% NaCl (w/v) |
| La CECT sigue estándares de calidad para garantizar la viabilidad, pureza y autenticidad de las cepas que conserva. La información mostrada en esta ficha procede de diversas fuentes. Algunas de las propiedades no han sido necesariamente contrastadas por la CECT |